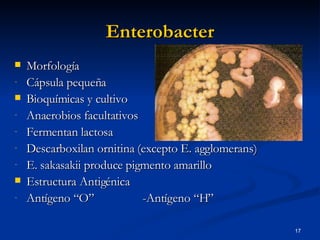
Enterobacter Morfología Cápsula pequeña Bioquímicas y cultivo Anaerobios facultativos  Fermentan lactosa Descarboxilan ornitina (excepto E. agglomerans) E. sakasakii produce pigmento amarillo Estructura Antigénica Antígeno “O” -Antígeno “H”

El documento describe las características del grupo KES (Klebsiella, Enterobacter, Serratia), bacterias Gram negativas oportunistas que causan infecciones nosocomiales. Explica la taxonomía, morfología, estructura antigénica, factores de virulencia, epidemiología y cuadros clínicos más comunes de cada género, así como su tratamiento y medidas de prevención.